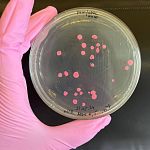

Правила раздела
Репетитор по химии 8-11 классов.
Здравствуйте! Меня зовут Анна, и я репетитор по химии для учеников 8-11 классов. Если химия кажется вам скучным набором формул и непонятных реакций, давайте вместе посмотрим на этот предмет под другим углом! Я помогу не только подтянуть оценки, но и по-настоящему разобраться в теме, чтобы каждая задача стала интересной головоломкой, а не стрессом????
Почему я могу быть вам полезна?✨
• Фундаментальное образование и практика: Я учусь на 4 курсе РХТУ им. Д.И.
Менделеева - университета, который является флагманом химического образования в России. Моя специальность
- «Биотехнология». Но самое главное - я уже сегодня применяю свои знания в науке, работая в ФИЦ Биотехнологии РАН.
Для вас это значит, что я могу объяснить, как законы из школьного учебника работают в современных лабораториях и реальных исследованиях. Это превращает абстрактные понятия в нечто осязаемое и интересное.
• Целенаправленная методика преподавания. Я фокусируюсь на нескольких ключевых направлениях:
1. Разбор домашних заданий и текущих тем:
Устраним пробелы, чтобы ученик уверенно чувствовал себя на уроках.
2. Качественная подготовка к контрольным и самостоятельным: Закрепим материал и отработаем задания, похожие на школьные.
3. Систематизация знаний: Помогу выстроить четкую картину предмета, чтобы новые темы не вызывали затруднений.
Моя главная цель - не просто «натаскать» на тесты, а воспитать интерес к предмету и научить логически мыслить. Я убеждена, что понимание химии открывает двери в мир современных профессий и инноваций.
Занятия провожу онлайн. Стоимость: 700₽ за академический час.
Готова ответить на все ваши вопросы и помочь полюбить химиЮ!
Для связи пишите в телеграмм. +79261245607
| Автор: | bangwaves |
| Тел.: | |
| E-mail: | w.bangwaves@gmail.com |
| Фото: |
Изменено: 15 января 22:22